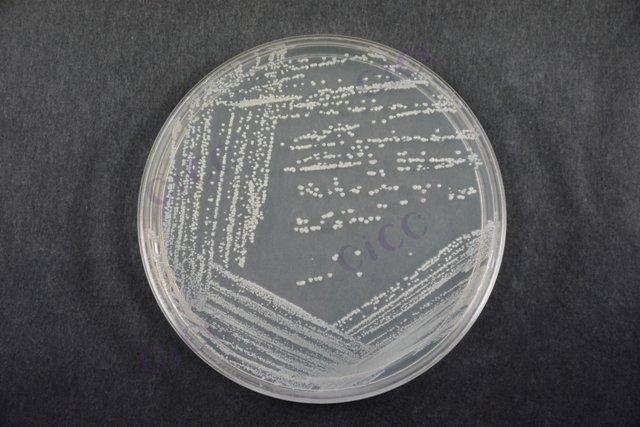
金黄色葡萄球菌 Staphylococcus aureus CICC 23656 Staphylococcus aureus

金黄色葡萄球菌 Staphylococcus aureus CICC 23656 Staphylococcus aureus
-
金黄色葡萄球菌 Staphylococcus aureus CICC 10473 Staphylococcus aureus
CICC 10473 | 见证书
-
金黄色葡萄球菌 Staphylococcus aureus CICC 10001 Staphylococcus aureus
CICC 10001 | 见证书
-
金黄色葡萄球菌 Staphylococcus aureus CICC 10145 Staphylococcus aureus
CICC 10145 | 见证书
-
金黄色葡萄球菌 Staphylococcus aureus CICC 10201 Staphylococcus aureus
CICC 10201 | 见证书
-
金黄色葡萄球菌 Staphylococcus aureus CICC 10301 Staphylococcus aureus
CICC 10301 | 见证书
-
金黄色葡萄球菌 Staphylococcus aureus CICC 10306 Staphylococcus aureus
CICC 10306 | 见证书
-
金黄色葡萄球菌 Staphylococcus aureus CICC 10307 Staphylococcus aureus
CICC 10307 | 见证书

说明书下载: 菌种说明书 打管说明书
您正在浏览的产品:金黄色葡萄球菌 Staphylococcus aureus CICC 23656
手机版:金黄色葡萄球菌 Staphylococcus aureus CICC 23656
本公司销售的所有产品仅供实验科研使用,不用于人体及临床诊断。
2. 平板计数法:直接接种Baird-Parker琼脂,典型菌落计算含量(适用于≥100 CFU/g的样品)
3. MPN法:通过三步增菌流程进行最可能数估算(适用于<100 CFU/g的样品)[9]
2. 平板计数法:定量范围10-1500 CFU/g,检出限10 CFU/g
3. MPN法:检测范围0-1100 MPN/g,报告限<3.0 MPN/g[9]
2. 培养基质控:7.5%氯化钠肉汤需验证葡萄球菌生长能力,Baird-Parker琼脂需保证典型菌落特征
3. 样品处理需在生物安全柜内完成,防止交叉污染[9]
2. 选择性增菌:36℃培养24h后转种Baird-Parker平板
3. 分离培养:35℃需氧培养45-48h观察典型菌落(黑色具晕圈)
4. 确证试验:革兰染色镜检、血浆凝固酶试验、耐热核酸酶检测[9]
2. 食品基质复杂样品需增加甘露醇发酵试验
3. 冷冻样品需在45℃以下快速解冻后立即检测
4. 定量检测需保证菌落数在30-300 CFU的计数有效区间[9]
以上信息仅供参考,请以相应标准的原文为准!